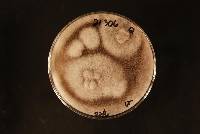
Fusarium oxysporum image
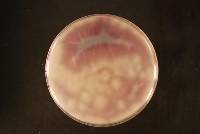
Fusarium oxysporum image
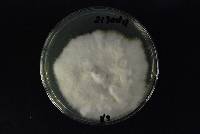
Fusarium oxysporum image
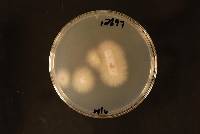
Fusarium oxysporum image
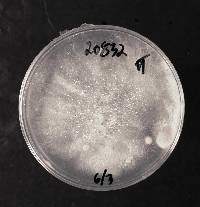
Fusarium oxysporum image
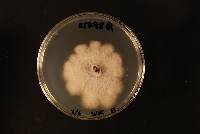
Fusarium oxysporum image
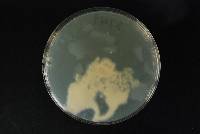
Fusarium oxysporum image
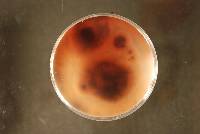
Fusarium oxysporum image

Fusarium oxysporum
|
Fusarium oxysporum
 (redirected from: Fusarium oxysporum f. vasinfectum (G.F. Atk.) W.C. Snyder & H.N. Hansen) (redirected from: Fusarium oxysporum f. vasinfectum (G.F. Atk.) W.C. Snyder & H.N. Hansen) |
|
|
Family: Nectriaceae
[Cylindrophora albedinis Kill. & Maire, moreFusarium albedinis (Kill. & Maire) Malençon, Fusarium angustum Sherb., Fusarium apii P.E. Nelson & Sherb., Fusarium asparagi Delacr., Fusarium batatas Wollenw., Fusarium batatas var. vanillae Tucker, Fusarium bulbigenum Cooke & Massee, Fusarium bulbigenum var. apii (P.E. Nelson & Sherb.) Raillo, Fusarium bulbigenum var. batatas Wollenw., Fusarium bulbigenum var. lycopersici (Sacc.) Wollenw. & Reinking, Fusarium bulbigenum var. niveum (E.F. Sm.) Wollenw., Fusarium bulbigenum var. pisi (Linford) Raillo, Fusarium bulbigenum var. tracheiphilum (E.F. Sm.) Wollenw., Fusarium carthami Klis. & Houston, Fusarium cepae Hanzawa, Fusarium conglutinans Wollenw., Fusarium conglutinans var. betae D. Stewart, Fusarium conglutinans var. callistephi Beach, Fusarium cubense E.F. Sm., Fusarium cubense var. inodoratum E.W. Brandes, Fusarium cucumerinum Berk. & Broome, Fusarium dianthi Prill. & Delacr., Fusarium lagenariae (Schwein.) Sacc., Fusarium lateritium f. ciceris (Padwick) Erwin, Fusarium lini Remer, Fusarium lycopersici (Sacc.) Wollenw., Fusarium merismoides f. ciceris (Padwick) Subram., Fusarium niveum McAlpine, Fusarium orthoceras Jacz., Fusarium orthoceras var. apii (P.E. Nelson & Sherb.) Wollenw. & Reinking, Fusarium orthoceras var. betae (D. Stewart) Padwick, Fusarium orthoceras var. callistephi (Beach) Padwick, Fusarium orthoceras var. ciceris Padwick, Fusarium orthoceras var. conglutinans (Wollenw.) Padwick, Fusarium orthoceras var. gladioli L. McCulloch, Fusarium orthoceras var. lentis Vasudeva & Sriniv., Fusarium orthoceras var. pisi Linford, Fusarium oxysporum f. apii (P.E. Nelson & Sherb.) W.C. Snyder & H.N. Hansen, Fusarium oxysporum f. batatas (Wollenw.) W.C. Snyder & H.N. Hansen, Fusarium oxysporum f. betae (D. Stewart) W.C. Snyder & H.N. Hansen, Fusarium oxysporum f. callistephi (Beach) W.C. Snyder & H.N. Hansen, Fusarium oxysporum f. cepae (Hanzawa) W.C. Snyder & H.N. Hansen, Fusarium oxysporum f. conglutinans (Wollenw.) W.C. Snyder & H.N. Hansen, Fusarium oxysporum f. cubense (E.F. Sm.) W.C. Snyder & H.N. Hansen, Fusarium oxysporum f. dianthi (Prill. & Delacr.) W.C. Snyder & H.N. Hansen, Fusarium oxysporum f. gladioli Toovey, Fusarium oxysporum f. lini (Bolley) W.C. Snyder & H.N. Hansen, Fusarium oxysporum f. lycopersici (Sacc.) W.C. Snyder & H.N. Hansen, Fusarium oxysporum f. melonis W.C. Snyder & H.N. Hansen, Fusarium oxysporum f. niveum (E.F. Sm.) W.C. Snyder & H.N. Hansen, Fusarium oxysporum f. perniciosum (Hepting) Toole, Fusarium oxysporum f. pisi (Linford) W.C. Snyder & H.N. Hansen, Fusarium oxysporum f. spinaciae (Sherb.) W.C. Snyder & H.N. Hansen, Fusarium oxysporum f. tracheiphilum (E.F. Sm.) W.C. Snyder & H.N. Hansen, Fusarium oxysporum f. vasinfectum (G.F. Atk.) W.C. Snyder & H.N. Hansen, Fusarium oxysporum subsp. lycopersici Sacc., Fusarium oxysporum var. albedinis (Kill. & Maire) Malençon, Fusarium oxysporum var. aurantiacum (Link) Wollenw., Fusarium oxysporum var. cepae (Hanzawa) Raillo, Fusarium oxysporum var. cubense (E.F. Sm.) Wollenw., Fusarium oxysporum var. dianthi (Prill. & Delacr.) Raillo, Fusarium oxysporum var. gladioli Massey, Fusarium oxysporum var. lycopersici Sacc., Fusarium oxysporum var. meniscoideum Bugnic., Fusarium oxysporum var. orthoceras (Appel & Wollenw.) Bilai, Fusarium oxysporum var. pisi (C.J.J. Hall) Raillo, Fusarium perniciosum Hepting, Fusarium redolens f. spinaciae (Sherb.) Subram., Fusarium spinaciae Sherb., Fusarium tracheiphilum Wollenw., Fusarium vasinfectum G.F. Atk., Fusarium vasinfectum var. egyptiacum Fahmy, Fusarium vasinfectum var. perniciosum (Hepting) Carrera, Fusisporium lagenariae Schwein.] |
|